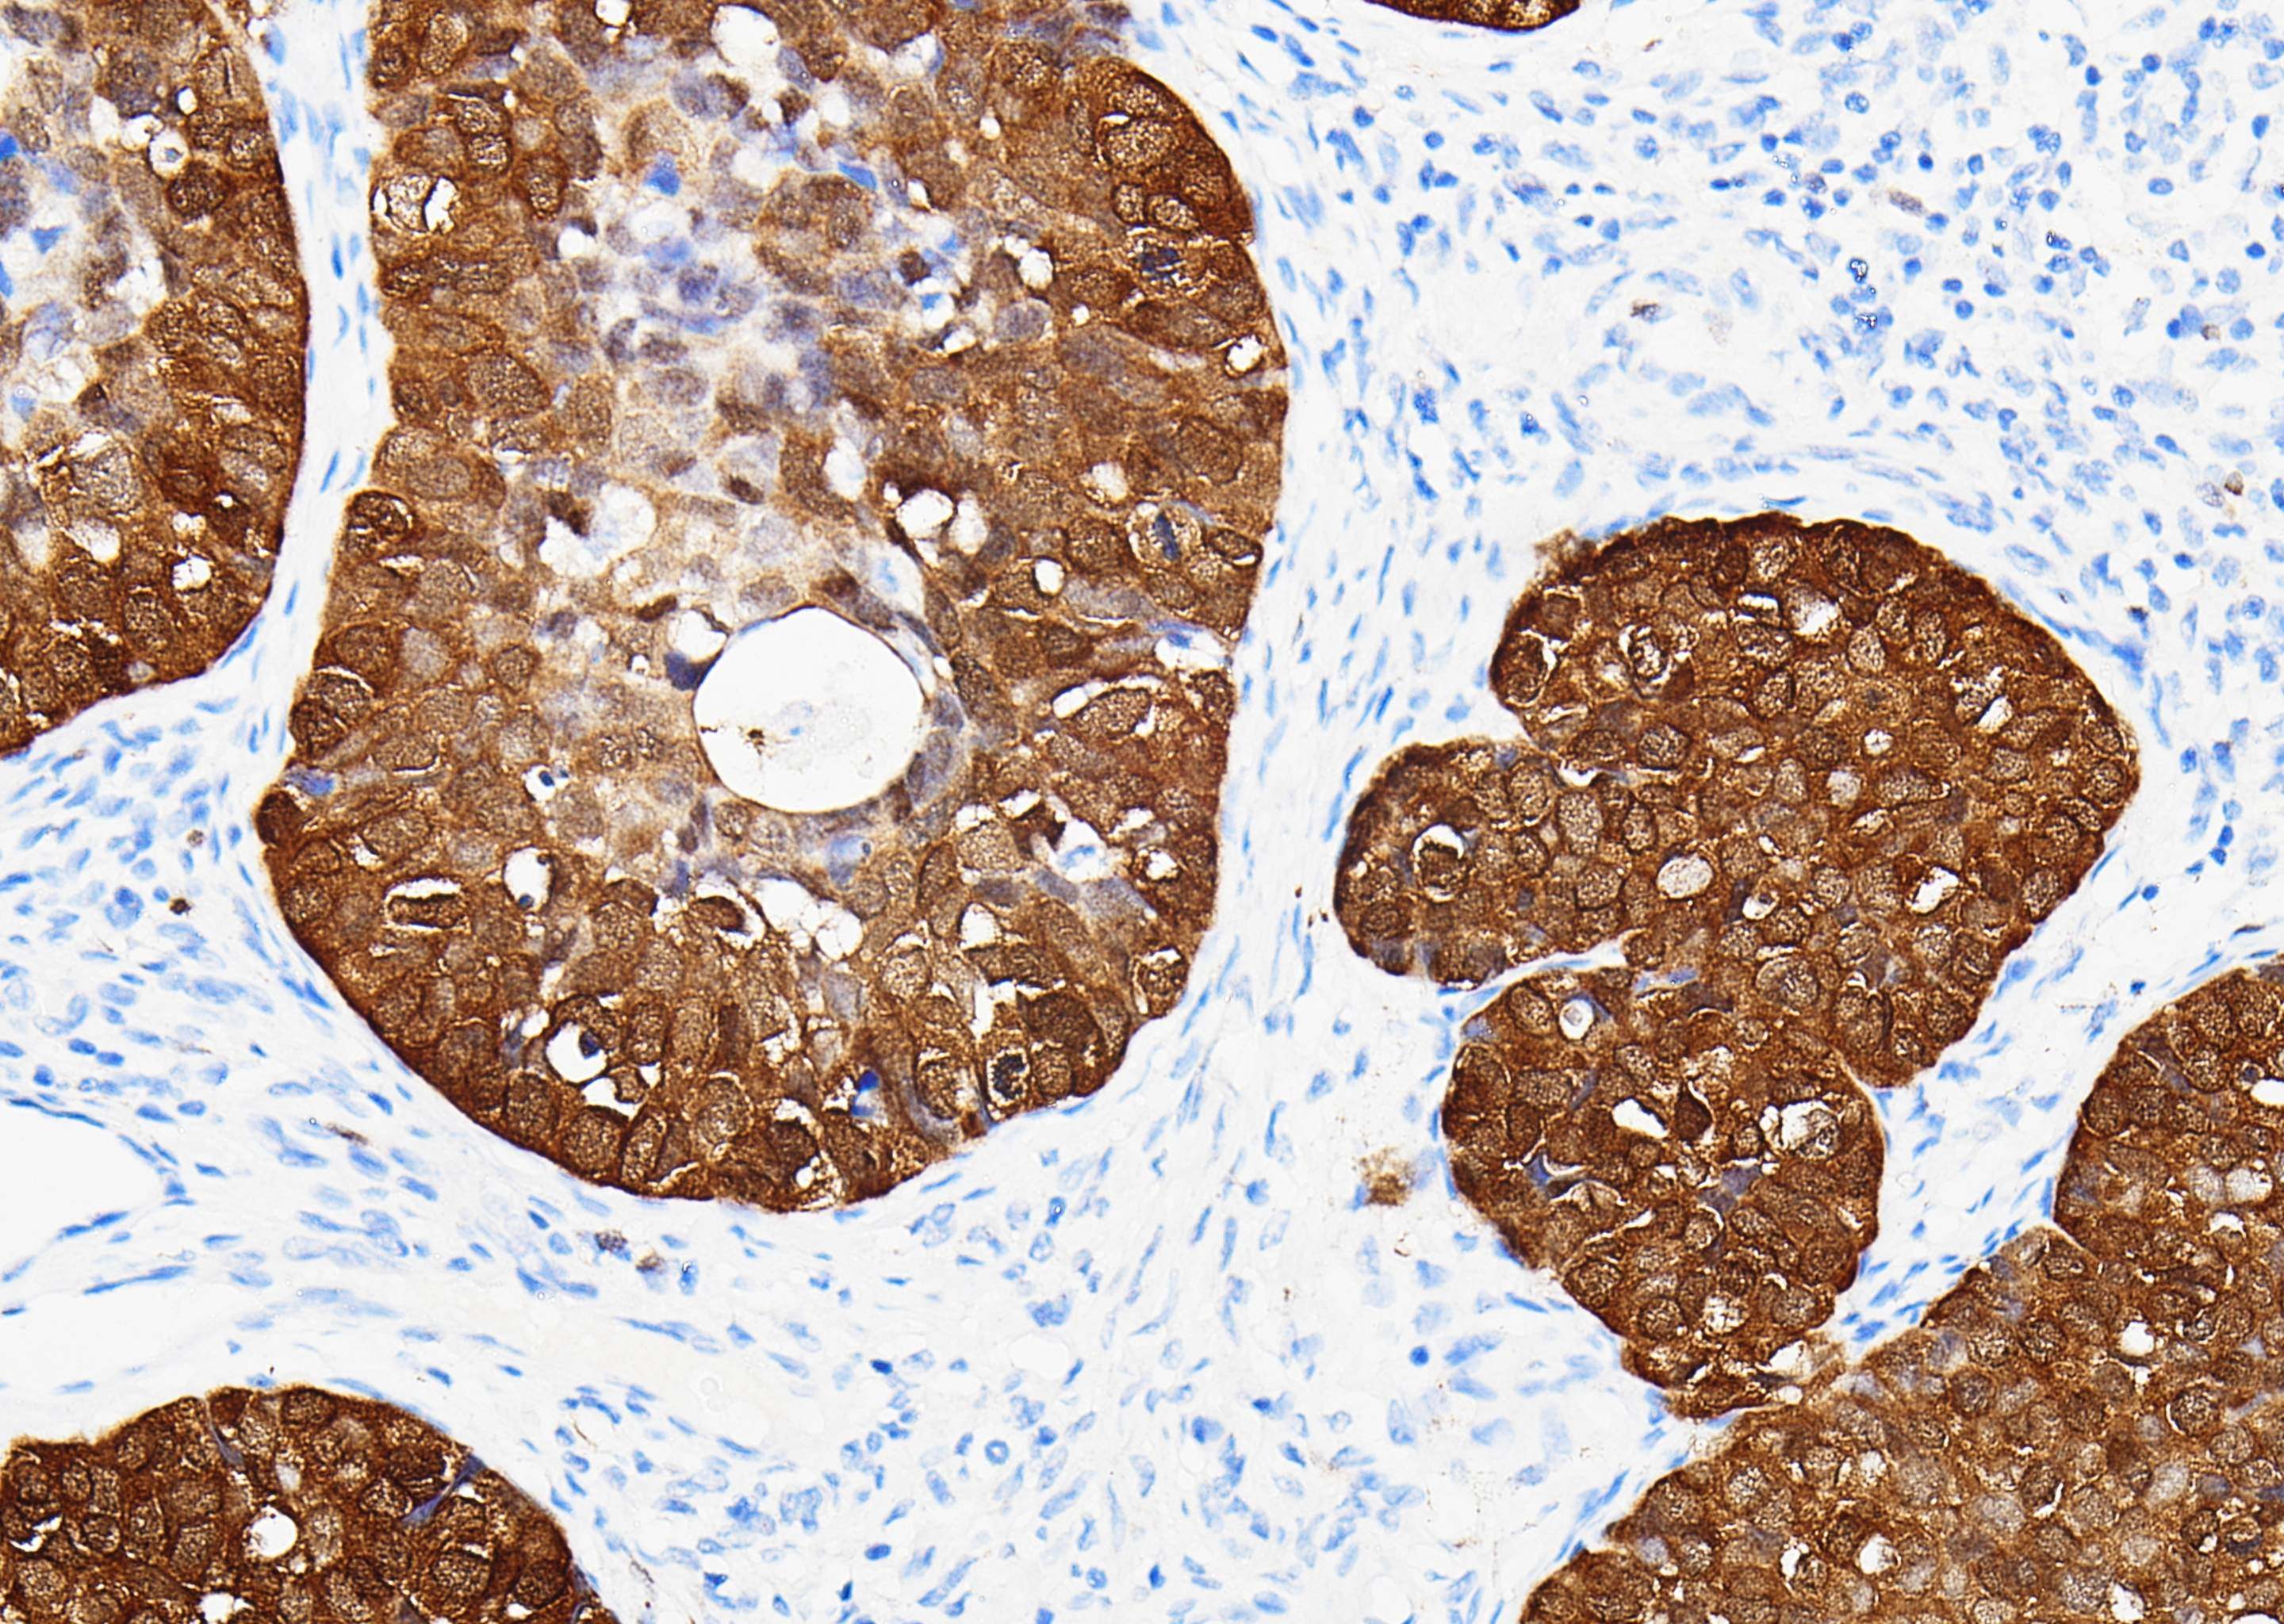
p16

Caldesmon
Caldesmon (钙调蛋白结合蛋白)是一种平滑肌肌动蛋白和钙调节蛋白的结合蛋白,位于细肌丝,调节 肌动蛋白和肌球蛋白的相互作用,主要存在于平滑肌细胞。Caldesmon 可用于正常平滑肌细胞及其肿瘤的标记,真性平滑肌肿瘤与肌纤维母细胞瘤、卵巢/腹膜浆液性乳头状癌与上皮样间皮瘤的鉴别,与CD10 联用 可用于子宫内膜间质肉瘤与子宫平滑肌肿瘤的鉴别诊断。
参数
| 样本要求 | 福尔马林固定,石蜡包埋的组织切片;丙酮固定的冷冻切片 |
|---|---|
| 免疫原 | 人Caldesmon合成肽 |
| 细胞定位 | 细胞质 |
| 主要成分 | 鼠抗人Caldesmon免疫组化单克隆抗体,0.01M PBS,1%BSA,0.05%ProClin300 |
| 储存条件 | 2-8℃ |
| 有效期 | 24个月 |
| 规格(手工工作液) | 3mL/瓶;6mL/瓶 |
您需要任何帮助?
我们会尽快为您解决